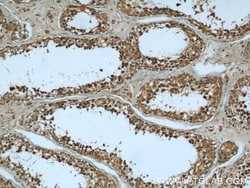
KHSRP Rabbit anti-Human, Mouse, Rat, Polyclonal, Proteintech:Antibodies:Primary
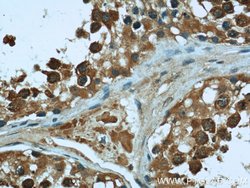
KHSRP Rabbit anti-Human, Mouse, Rat, Polyclonal, Proteintech:Antibodies:Primary

missing translation for 'onlineSavingsMsg'
Learn More
Learn More
KHSRP Rabbit anti-Human, Mouse, Rat, Polyclonal, Proteintech
Rabbit Polyclonal Antibody
145.00€ - 410.00€
Especificaciones
| Antigen | KHSRP |
|---|---|
| Concentration | 0.52 mg/mL |
| Applications | Immunohistochemistry (Paraffin), Western Blot, Immunofluorescence, Immunocytochemistry |
| Classification | Polyclonal |
| Conjugate | Unconjugated |
| Código de producto | Marca | Quantity | Precio | Cantidad y disponibilidad | |||||
|---|---|---|---|---|---|---|---|---|---|
| Código de producto | Marca | Quantity | Precio | Cantidad y disponibilidad | |||||
|
16836875
|
Proteintech
55409-1-AP-20UL |
20 μL |
145.00€
20µL |
Please sign in to purchase this item. Need a web account? Register with us today! | |||||
|
16826875
|
Proteintech
55409-1-AP-150UL |
150 μL |
410.00€
150µL |
Please sign in to purchase this item. Need a web account? Register with us today! | |||||
Descripción
The KHSRP gene encodes a multifunctional RNA-binding protein implicated in a variety of cellular processes, including transcription, alternative pre-mRNA splicing, and mRNA localization.Especificaciones
| KHSRP | |
| Immunohistochemistry (Paraffin), Western Blot, Immunofluorescence, Immunocytochemistry | |
| Unconjugated | |
| Rabbit | |
| Rat, Human, Mouse | |
| Q3U0V1, Q92945, Q99PF5 | |
| 16549, 171137, 8570 | |
| Peptide | |
| Primary | |
| -20°C | |
| KHSRP |
| 0.52 mg/mL | |
| Polyclonal | |
| Liquid | |
| RUO | |
| PBS with 50% glycerol and 0.02% sodium azide; pH 7.3 | |
| FBP2, FUBP2, FUSE binding protein 2, KHSRP, KSRP, p75 | |
| Khsrp | |
| IgG | |
| Antigen Affinity Chromatography | |
| Antibody |
¿Detecta una oportunidad de mejora?Comparta una corrección de contenido
Corrección del contenido de un producto
Proporcione sus comentarios sobre el contenido del producto rellenando el siguiente formulario.
Título del producto